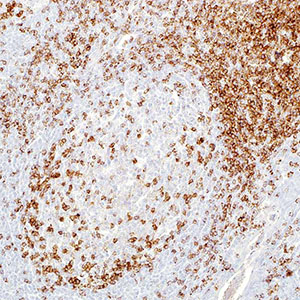
CD2

CD2 является одним из самых ранних антигенов Т-клеточной линии, возникающим во время дифференцировки Т-клеток. CD2 – общий Т-клеточный маркёр. Следовательно, антитело к CD2 используется для идентификации практически всех нормальных Т-лимфоцитов. Оно также очень полезно в исследованиях лимфоидных злокачественных новообразований, поскольку CD2 экспрессируется в большинстве лимфом и лейкемий из предшественников и зрелых Т-клеток. Как и другие общие Т-клеточные антигены, CD2 может не выявляться в некоторых неопластических Т-клеточных популяциях, особенно в периферических Т-клеточных лимфомах. В комбинации с антителом к CD25, антитело к CD2 может быть полезным при диагностике системного мастоцитоза и лейкемии из тучных клеток.
|
Купить Cell Marque CD2, а также другие реактивы, антитела и системы детекции от лучших мировых производителей вы всегда сможете в нашей компании. |
 |
|
 |
Наши преимущества:
Только качественные |
Минимально возможные |
Доставка по всей России с соблюдением температурного режима |
Полный пакет документов |
На данный момент мы сотрудничаем с ведущими зарубежными производителями лабораторных реактивов. Нашими клиентами являются как негосударственные, так и государственных учреждения, в том числе медицинские организации Москвы и других городов России. Для постоянных клиентов предусмотрена система скидок.








